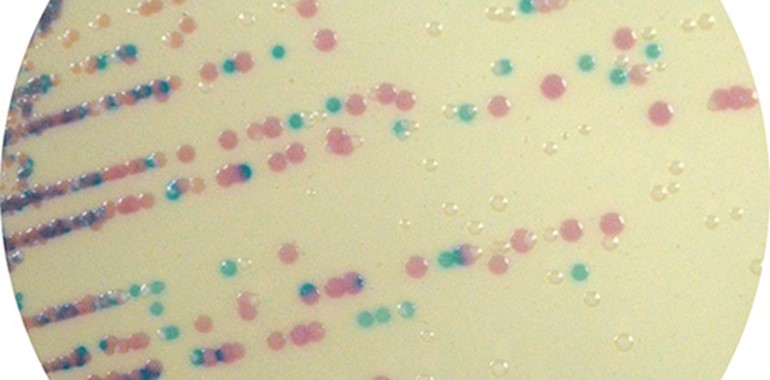

Entdecken Sie unser chromogenes Medium: CHROMagar™ Staphylococcus
Chromogenes Medium zur Isolierung und Differenzierung von Staphylococcus spp.
Mastitis-Erkrankungen können große Verluste in der Milchproduktion verursachen. Die am weitesten verbreitete Form dieser Krankheit ist die subklinische Mastitis. Sie kann zur verringerten Milchproduktion sowie einem erhöhten Risiko einer klinischen Mastitis während der Laktation führen. Die Kontrolle der Ausbreitung ansteckender, subklinischer Mastitis durch schnelle Identifizierung der verursachenden Erreger (Staphylococcus aureus und anderer Staphylococcus-Arten) ist daher unerlässlich für gezielte Kontrollmaßnahmen.
CHROMagar™ Staphylococcus ist ein selektives und differentielles chromogenes Medium für den qualitativen Direktnachweis und die Differenzierung von Staphylococcus spp. In Kombination mit CHROMagar™ Streptococcus und CHROMagar™ Mastitis GN wird CHROMagar™ Staphylococcus zu einem wichtigen Tool für den Nachweis von Krankheitserregern in Milchproben. Die Ergebnisse können nach 18-24 Stunden aerober Inkubation bei 35-37 °C interpretiert werden.
Vorteile des CHROMagar™ Staphylococcus:
- Leichte Herstellung
CHROMagar™ Staphylococcus enthält bereits alle zur Herstellung nötigen Komponenten im Pulver – es sind keine Supplemente erforderlich. Das herkömmliche Medium zum Nachweis von Staphylococcus spp. hingegen (Baird-Parker-Medium) muss nach dem Autoklavieren noch mit einer Emulsion aus Eigelb und Antibiotika versetzt werden. - Schnelles und einfaches Ablesen der Platten
CHROMagar™ Staphylococcus-Platten können bereits nach 24 h abgelesen werden, während dies bei Baird-Parker-Platten erst nach 48 h Inkubationszeit möglich ist. Außerdem ermöglicht CHROMagar™ Staphylococcus eine direkte Differenzierung von Staphylococcus-Spezies durch spezifische Färbung der Kolonien.
Den CHROMagar™ Staphylococcus erhalten Sie bei uns in folgenden Varianten:
CHROMagar™ Staphylococcus Fertigplatten
(gebrauchsfertige Platten, 20 Stück, Art. Nr. 201427)
CHROMagar™ Staphylococcus Trockennährmedium
(1 x 5 Liter, Art. Nr. 15CQ382)